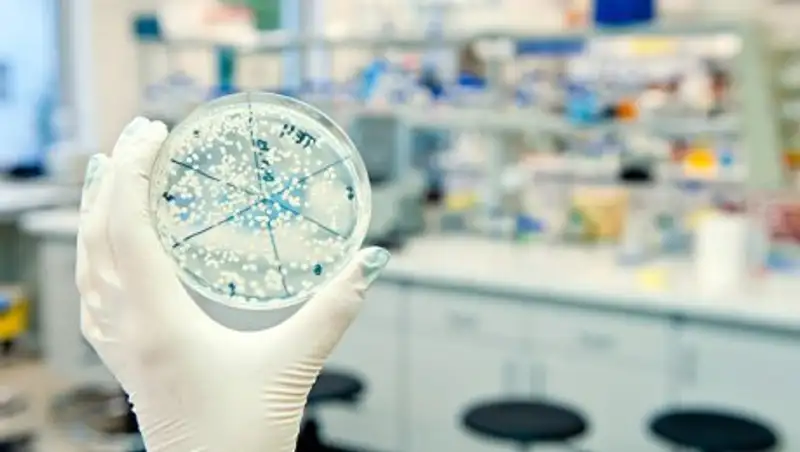
В Кыргызстане назвали причину отравления около 250 человек в ресторане

Бекшин: В ресторанах нужно смотреть не на зал, а на кухню
 zakon.kz
zakon.kz
Главный санврач рассказал, чем может быть опасен бешбармак в ресторанах.
На пресс-конференции в СЦК председатель Комитета охраны общественного здоровья Министерства здравоохранения РК - Главный государственный санитарный врач РК Жандарбек Бекшин рассказал об опасности проведения мероприятий в ресторанах, пишет .
"Мы, казахи, любим гостей. На наших мероприятиях в среднем по 200-300 человек. Многие заказчики в первую очередь смотрят на оформление зала и забывают, что самое главное – это кухня. Нужно смотреть, есть ли квалифицированные повара, достаточное количество официантов, есть ли условия для хранения сырья. Еще одна проблема возникает, когда приготовленное дома блюдо приносят в рестораны. Неизвестно, кто и в каких условиях это готовил", - прокомментировал Бекшин.
Поделитесь новостью
Читайте также
Если вы видите данное сообщение, значит возникли проблемы с работой системы комментариев. Возможно у вас отключен JavaScript